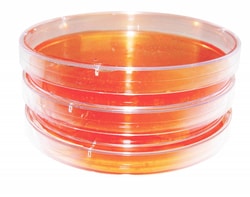
Research Products Corporation Disposable Petri Dishes, Sterile, 100 x 15

missing translation for 'onlineSavingsMsg'
Learn More
Learn More
Research Products Corporation Disposable Petri Dishes, Sterile, 100 x 15 mm, 20 per Sleeve, 500 per Case
Supplier: Research Products Corporation RPI 160265

Optically clear polystyrene dishes provide distortion free viewing of cultures. Covers have three venting lugs to optimize air circulation. Molded in ventilation ribs promote air circulation and reduce condensation during incubation procedures.
Dishes are radiation sterilized and packaged in sealed sleeves containing 20 dishes per sleeve and 500 dishes per case.